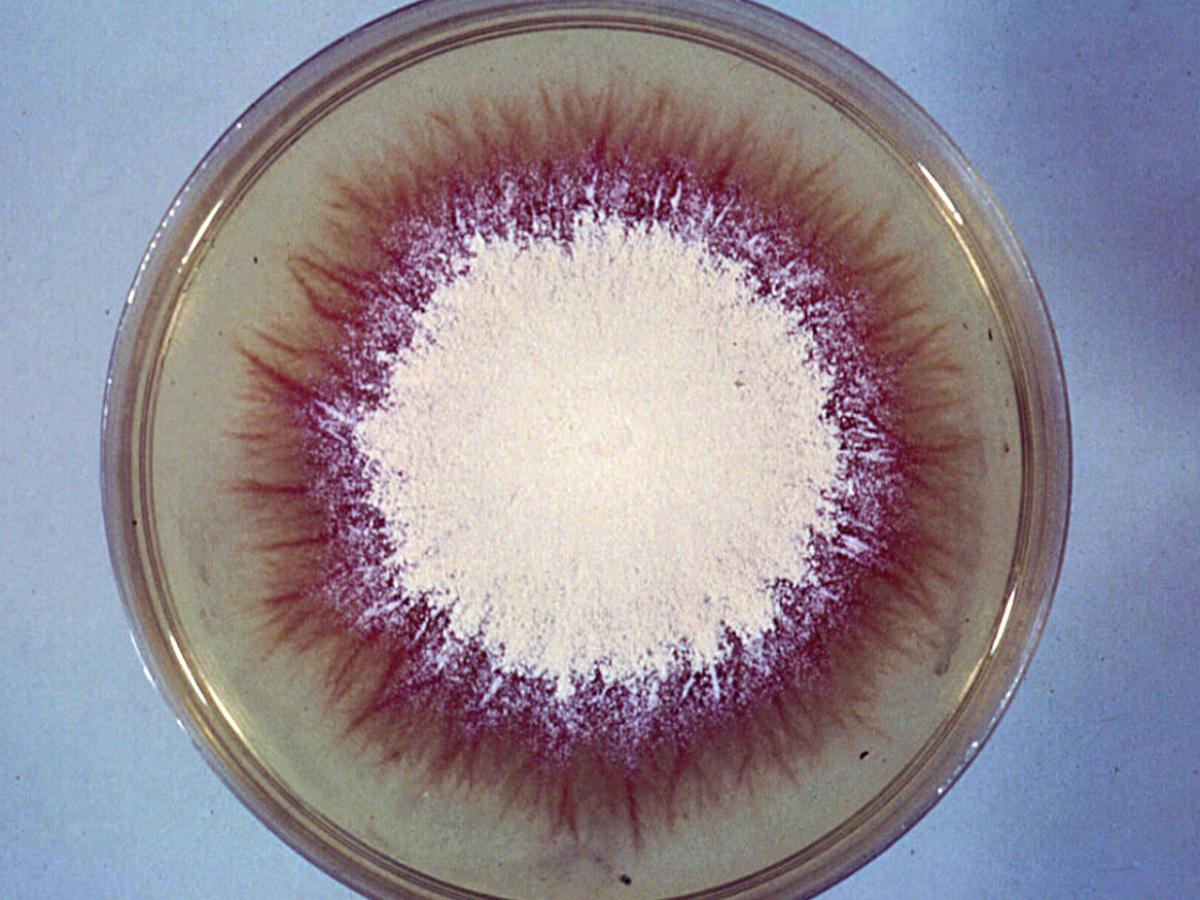
Culture

Status message
Correct! Excellent, you have really done well. Please find additional information below.
Unknown 24 = Trichophyton mentagrophytes
Direct microscopy (KOH mount): KOH mount of infected skin scales showing typical dermatophyte hyphae breaking up into arthroconidia.

Culture: On Sabouraud's dextrose agar, colonies are generally flat, white to cream in colour, with a powdery to granular surface. Some cultures show central folding or develop raised central tufts or pleomorphic suede-like to downy areas. Reverse pigmentation is usually a yellow-brown to reddish-brown colour.
Microscopy: Microconidia and macroconidia of T. mentagrophytes.

Microconidia of
T. mentagrophytes.

Spiral hyphae of
T. mentagrophytes.

Comment: T. mentagrophytes is the zoophilic dermatophyte with a world-wide distribution and a wide range of animal hosts including mice, guinea pigs, kangaroos, cats, horses, sheep and rabbits. Produces inflammatory skin or scalp lesions in humans, particularly in rural workers. Kerion of the scalp and beard may occur. Invaded hairs show an ectothrix infection but do not fluoresce under Wood's ultra-violet light.
About Trichophyton Back to virtual assessment